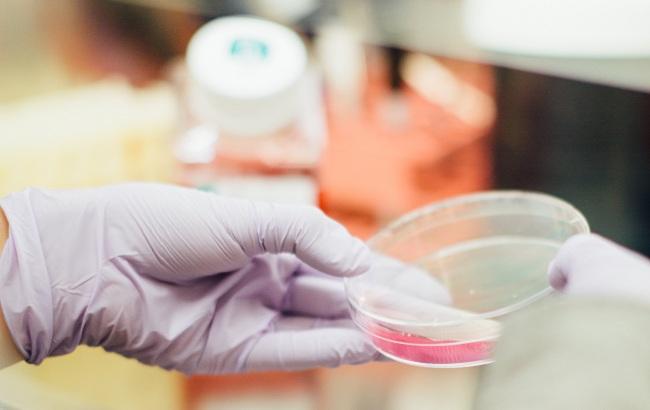

Ученые изобрели пластырь от инсульта
Фото: Препарат (unsplash.com/Drew Hays)
Фото: Препарат (unsplash.com/Drew Hays)
Использование пластыря в пути до больницы позволило снизить смертность более чем в два раза
Ученые из Великобритании разработали пластырь, который значительно увеличивает шансы на выживание в случае инсульта. Об этом сообщает издание The Guardian.
Инсульт обычно вызван сгустком артерии или разрывает кровеносный сосуд в мозге и вызывает постоянную неспособность примерно у четверти пациентов. Сообщается, что пластырь содержит тринитрат глицерина (ГТН), который снижает кровяное давление и открывает кровеносные сосуды, помогая уменьшить ущерб, причиненный в ближайшие минуты и часы после инсульта.
Небольшое исследование, в котором взяло участие около 40 пациентов доказало, что накладывание пластыря на плечо или спину пациента во время поездки в больницу вдвое уменьшило смертность от инсультов с 38% до 16%.
Изобретение ученых должно пройти еще несколько исследований. В случае успеха это может революционизировать лечение пациентов с инсультом в Великобритании в глобальном масштабе и может стать огромным шагом вперед в улучшении лечения инсульта, которое в настоящее время отстает от лечения сердечных приступов.
